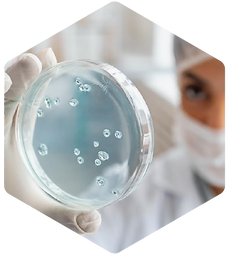
12-1-07_edited.png

top of page



En el Laboratorio Clínico Continental
Basada en las necesidades de nuestros pacientes y sus familias. Nuestras pruebas de laboratorio son realizadas con equipos de última tecnología, garantizando resultados confiables.
Buscamos generar experiencias de servicio humanizado y atención segura.

Ejes Estratégicos

Atención Centrada en el usuario

Humanización de la atención

Gestión clínica excelente

Gestión del riesgo

Gestión de la tecnología

Transformación cultural

Responsabilidad social

Política de tratamiento de datos


bottom of page